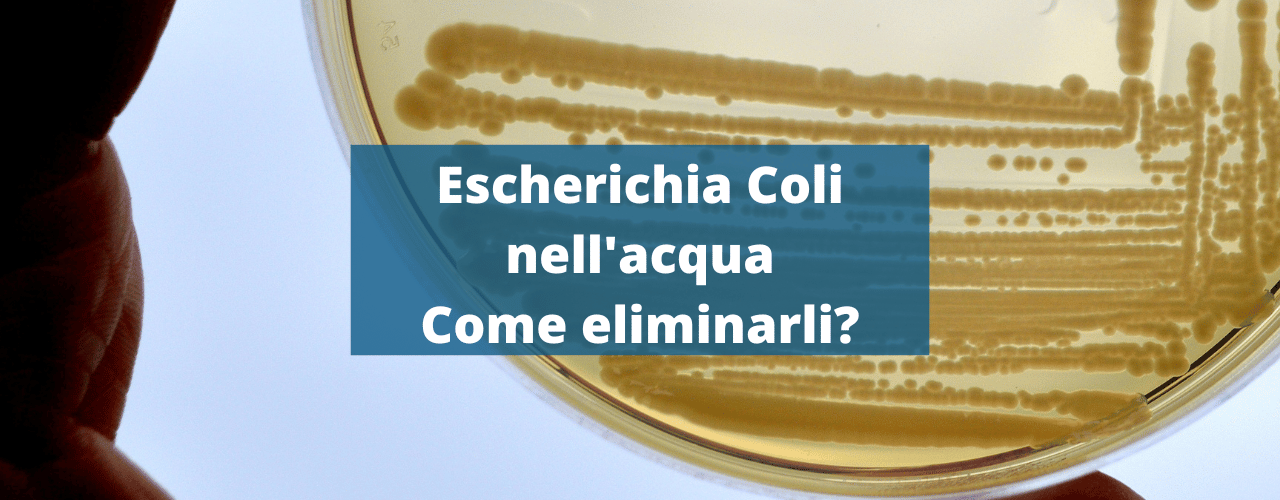
Escherichia Coli nell'acqua come eliminarli?

Sistemi per la depurazione dell’acqua in ceramica
Eivavie propone soluzioni per il trattamento naturale dell’acqua. I nostri filtri in ceramica esistono da quasi 200 anni e rimuovono più di 200 sostanze.

Calcola l’impatto positivo che puoi generare con un filtro per acqua Eivavie®
L’acquisto di un sistema di filtraggio acqua Eivavie può generare da subito un impatto positivo sulla singola persona o famiglia ma anche sul nostro pianeta. Scopri quanto puoi risparmiare all’anno con l’installazione di un depuratore sopra o sotto lavello Eivavie®. Compila i cambi editabili del calcolatore con il numero di componenti della tua famiglia e il consumo giornaliero di litri d’acqua a persona.
Calcolatore di risparmio Eivavie®
0 persone hanno già calcolato il loro risparmio!
Scopri i risparmi che potresti ottenere acquistando un sistema di filtrazione acqua Eivavie®!
LEGENDA
Risparmio economico*: il calcolatore calcola il risparmio annuale che otterresti non acquistando acqua in bottiglia, ma utilizzando un sistema di filtrazione Eivavie. Viene sottratto il costo dei filtri, e il risultato viene espresso in euro.
*Per il calcolo del risparmio economico annuo si considera il costo sostenuto per l’acquisto di acqua in bottiglia di PET (polietilene tereftalato) ad un prezzo medio di 0,20€/L ed il costo per la gestione del depuratore Eivavie® (sostitutizione della candela ceramica Advanced Ceramicae ogni 6 mesi).
Bottiglie di Plastica Risparmiate: il calcolatore stima il numero di bottiglie di plastica da 1,5 litri che non dovrai più acquistare grazie all’uso di acqua filtrata. Questo valore è importante per capire l’impatto ambientale del tuo risparmio.
Tempo Risparmiato: questo calcolo indica il tempo che risparmieresti non dovendo acquistare e trasportare bottiglie di plastica da 1,5 litri. Il tempo è espresso in ore e si basa sul numero di casse di bottiglie che non dovrai più comprare.
Fatica Risparmiata: il sistema calcola la “fatica” che risparmi evitando di fare acquisti di bottiglie pesanti e di trasportarle. In questo caso, viene indicato come “infinita” per sottolineare quanto il risparmio in termini di sforzo fisico sia significativo.
CO2 Risparmiata: calcola la riduzione delle emissioni di CO2 derivante dall’eliminazione delle bottiglie di plastica. Ogni bottiglia di plastica ha un impatto ambientale, e il calcolatore stima quanta CO2 non verrà emessa grazie all’uso del sistema di filtrazione Eivavie®.
Consulenza personalizzata Eivavie®
Il nostro team è a disposizione per fornirti una consulenza dedicata e specifica per capire qual è la soluzione più adatta per le tue esigenze. Contattaci, valuteremo le caratteristiche della tua acqua e capiremo qual è il filtro migliore e quali modalità di erogazione sono disponibili
Perche’ scegliere i sistemi per la depurazione dell’acqua in ceramica?
La tecnologia di filtrazione Eivavie utilizza tre materiali naturali altamente efficaci: ceramica microporosa, carbone vegetale ottenuto dal guscio di noce di cocco e zeolite. Questo sistema avanzato rimuove oltre 200 sostanze contaminanti, garantendo un’acqua pura e sicura, senza alterarne la composizione minerale.
I filtri Eivavie offrono numerosi vantaggi:
✔️ Non richiedono elettricità, rendendoli pratici ed ecologici.
✔️ Non producono sprechi d’acqua, evitando consumi inutili.
✔️ Preservano i sali minerali essenziali, fondamentali per il benessere dell’organismo.
✔️ La zeolite migliora l’efficacia della filtrazione, contribuendo a rimuovere metalli pesanti e altre impurità.
Il processo di purificazione dell’acqua avviene in tre fasi:
1️⃣ Filtrazione meccanica: l’acqua viene spinta attraverso la ceramica microporosa, che trattiene impurità, sedimenti e microplastiche.
2️⃣ Adsorbimento e purificazione: l’acqua passa poi attraverso uno strato di carbone vegetale e zeolite, che elimina contaminanti chimici, cloro, pesticidi, metalli pesanti e neutralizza odori e sapori indesiderati.
3️⃣ Erogazione sicura: l’acqua depurata viene convogliata attraverso il foro centrale della candela filtrante ed erogata attraverso l’uscita della filettatura del filtro.
Il risultato? Un’acqua pura, priva di sostanze nocive, ricca di minerali essenziali e senza sprechi!


I prodotti più venduti
-

Candela filtrante Eivavie® Advanced Ceramicae 1/4″ bsp
€49,90 IVA inclusa -

Candela filtrante Eivavie® Advanced Ceramicae SI 1/4″ bsp
€59,90 IVA inclusa -
 Novità!
Novità!Candela filtrante Eivavie® Ultimate Ceramicae Gravity
€48,90 IVA inclusa -
 Prodotto del mese!
Prodotto del mese!Depuratore acqua portatile a gravità Eivavie® in acciaio inox da 8.5 litri
Da €229,00 IVA inclusa -
 Novità!
Novità!Candela filtrante Eivavie® Ultimate Ceramicae 1/4″ bsp
€69,90 IVA inclusa -

Unità di filtrazione acqua sotto lavello con miscelatore a tre vie
Da €629,00 -

Unità di filtrazione acqua sotto lavello con rubinettino aggiuntivo
Da €389,00 -

Depuratore acqua portatile a gravità in acciaio inox da 1 litro
Da €139,00 IVA inclusa -

Depuratore acqua Sopra Lavello Eivavie® Cts in acciaio inox
Da €269,00 IVA inclusa -

Depuratore acqua Sopra Lavello Eivavie® Ctp in plastica alimentare
Da €179,00 IVA inclusa -

Unità di filtrazione acqua sotto lavello con miscelatore a tre vie – UNITA’ DUO
Da €799,00 -

Unità di filtrazione acqua sotto lavello con rubinettino aggiuntivo – UNITA’ DUO
Da €559,00
Offerta del mese – Maggio 2026
Ogni mese selezioniamo un prodotto da proporti ad un prezzo molto vantaggioso!

A maggio 2026 abbiamo scelto il sistema di filtrazione sopra lavello CTS Duo in acciaio inox: una soluzione pratica e autonoma per ottenere acqua buona e sicura grazie alla doppia filtrazione.
Accanto alla candela ceramica, puoi selezionare il prefiltro più adatto alle tue esigenze: nitrati, calcare, fluoruri, impurità o arsenico. L’installazione è immediata — bastano 5 minuti, senza attrezzi né interventi tecnici.
Il CTS Duo di Eivavie® è progettato per chi desidera una filtrazione mirata e più avanzata. Se vivi in un’area con alta presenza di nitrati, puoi abbinarvi il prefiltro specifico; in zone come Viterbo, è possibile valutare quello per l’arsenico; mentre per ridurre la durezza dell’acqua, la scelta ideale è il prefiltro anticalcare.
Pensato per l’uso domestico, è una soluzione semplice ma altamente efficace, perfetta per chi cerca un sistema fai-da-te affidabile.
Il sistema include una pratica valvola deviatrice che consente di scegliere tra acqua filtrata e acqua di rete. La struttura è composta da due alloggiamenti collegati:
- l’acqua entra prima nel contenitore del prefiltro
- passa poi al filtro in ceramica e carbone vegetale pressato
- infine viene erogata attraverso un elegante collo di cigno orientabile a 180°
Se cerchi un dispositivo performante, pronto all’uso e capace di migliorare concretamente la qualità dell’acqua di casa, il CTS Duo sopra lavello Eivavie è una scelta solida e intelligente.
€329,00 €289,00
Giorno/i
:
Ora/e
:
Minuto/i
:
Secondo/i
Acqua buona. Da subito.
Lo colleghi al rubinetto di casa tua in soli 5 minuti!– Elimina impurità, microplastiche e residui chimici
– Installazione fai da te
– Doppia filtrazione per prestazioni superiori
Approfondimento: il problema dei PFAS
I PFAS (Perfluoroalchilici) sono un gruppo di sostanze chimiche artificiali che sono state utilizzate in molte applicazioni industriali e commerciali per le loro proprietà impermeabili, antiaderenti e resistenti al fuoco.
I PFAS sono inoltre persistenti nell’ambiente e si accumulano nel corpo umano e negli animali, per questo motivo vengono considerati delle sostanze altamente tossiche e inquinanti. A causa dei loro effetti dannosi, molte nazioni e organizzazioni internazionali hanno adottato regolamenti per limitare l’uso e la diffusione di questi composti.
I PFAS sono stati rilevati in molte fonti di acqua potabile in tutto il mondo, comprese le acque sotterranee, le acque superficiali e le forniture di acqua pubblica.
Rimuovere i PFAS dall’acqua è possibile attraverso i filtri in ceramica e carbone vegetale pressato di Eivavie.

Manifesto
La nostra terra, la casa che condividiamo, è soffocata dalla plastica. La crisi climatica non è più una minaccia lontana, ma una ferita aperta che richiede azioni immediate, concrete, quotidiane.
Il tempo per rimandare è finito. È il momento di cambiare abitudini, a partire da una delle più semplici e impattanti: dire addio all’acqua in bottiglia.
Il futuro è già qui, ed è fatto di scelte consapevoli.
Il futuro è l’acqua a metro zero: l’acqua del rubinetto, migliorata attraverso sistemi di filtrazione sostenibili.
Eivavie nasce da questa visione.
Progettiamo e realizziamo soluzioni per il trattamento dell’acqua basate su una filtrazione selettiva: rimuoviamo ciò che non serve, preservando i minerali naturalmente presenti.
Ogni nostro prodotto è pensato per ridurre l’impatto sul pianeta, eliminare gli sprechi e restituire valore a ciò che abbiamo già: l’acqua di casa.
Crediamo in un modo diverso di consumare, più responsabile e più vicino alla natura.
Crediamo che il cambiamento passi dalle scelte di ogni giorno.
Eivavie ti invita ad agire. Ora.
Le video recensioni di Eivavie
Vuoi ricevere una consulenza personalizzata?
La ricerca di un sistema di depurazione dell’acqua adatto alle proprie esigenze può essere frustrante: diverse tecnologie disponibili, molteplici modalità di erogazione, formule commerciali poco chiare. In generale per un non addetto ai lavori è davvero difficile orientarsi e scegliere il prodotto migliore in base alla propria acqua e alle preferenze estetiche e funzionali. Se anche tu stai avendo difficoltà nel trovare un prodotto che risolva i tuoi problemi, non esitare a contattarci. Eivavie ha ormai diversi anni di esperienza nel settore del trattamento naturale dell’acqua e siamo a disposizione per guidarti in una scelta importante, in quanto non dimentichiamolo mai, l’acqua è la base della vita e della nostra piramide alimentare.
Leggi gli ultimi articoli del nostro Blog
Escherichia coli nell acqua: Come eliminarli?
Introduzione I batteri indicatori: Cosa sono? Escherichia coli: Batterio indicatore per eccellenza La soluzione: Come eliminare escherichia coli nell acqua Introduzione Escherichia coli nell acqua: sono i primi batteri che vengono in mente quando si parla di…

I filtri in ceramica per la depurazione dell’acqua
I filtri in ceramica per depurare l’acqua sono una soluzione ecologica, economica ed efficace. Scopri le caratteristiche di questa tecnologia naturale.

I vantaggi di un impianto depuratore acqua domestico
Introduzione Cos’è un impianto depuratore? Quali sono i vantaggi di avere un impianto depuratore acqua domestico? Perché scegliere un impianto depuratore acqua naturale? 1. Introduzione Scopri i molteplici vantaggi di un impianto depuratore acqua domestico e unisciti…

Depuratore acqua casalingo o depuratore acqua portatile?
Introduzione Il depuratore acqua casalingo Il depuratore d’acqua portatile Conclusione Introduzione Depuratore acqua casalingo o depuratore acqua portatile? Se stai valutando l’acquisto di un depuratore per il trattamento dell’acqua del tuo rubinetto, puoi scegliere…
 SPEDIZIONE GRATIS
SPEDIZIONE GRATIS
Per ordini superiori a 70€
 SUPPORTO TELEFONICO
SUPPORTO TELEFONICO
Dal lunedì al venerdì 8:00-12:00 14:00-18:00
 SODDISFATTI O RIMBORSATI
SODDISFATTI O RIMBORSATI
Puoi restituire il prodotto entro 14 giorni
 SCONTI PER ADDETTI
SCONTI PER ADDETTI
Scontistiche su misura per installatori e rivenditori

















